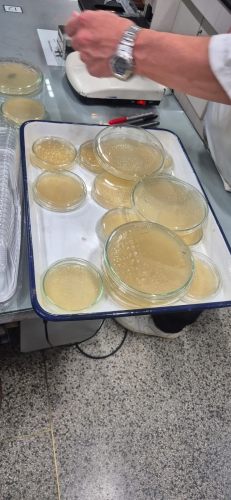
6

AULA DE MICROSCOPIA: COMPREENDENDO OS MICRO-ORGANISMOS 24/03/2026 - 09:53
Na data de 17 de março, as estudantes da turma 4o Saúde Bucal, Curso Técnico
Subsequente Noturno do Colégio Estadual do Paraná, realizaram aula prática de
microscopia no Laboratório de Biologia. A aula foi planejada pela professora Tatina Kreia e
desenvolvida pelo professor laboratorista Eugenio Lyznik Junior.
O objetivo principal da aula foi colocar as estudantes em contato com o
microscópio, estudando diferentes tipos celulares, manipulando e preparando lâminas,
entendendo o quão minúsculos são os micro-organismos.
Nessa aula, os conteúdos abordados foram microscópio e seus componentes,
tipos celulares, tipos de bactérias, tipos de microrganismos presentes nos diferentes tipos
de lugares (sendo que esse tema terá continuação na próxima aula).
Importante mencionar que a microscopia é o conjunto de técnicas que utilizam
microscópios para ampliar imagens de objetos, células ou tecidos minúsculos, invisíveis a
olho nu.
Foi possível observar que as estudantes participaram com bastante interesse de
todas as atividades propostas pelo professor Eugenio, direcionando muitas perguntas
interessantes. Notou-se uma empolgação na realização da atividade, mostrando-se
motivadas pela continuidade do resultado da coleta que fizeram no final da aula.
Despertou grande curiosidade para visualizarem quais micro-organismos encontrarão nos
diferentes lugares que coletaram.
Também foi possível avaliar que as estudantes compreenderam a importância da
biossegurança no dia a dia nos seus trabalhos, uma vez que convivem com diversos
microrganismos e precisam minimizar seus efeitos para uma melhor qualidade nos
tratamentos prestados aos pacientes odontológicos.
Ao final da atividade, constatou que ela foi muito proveitosa e que as
estudantes gostariam de ter mais atividades como essa, para melhor assimilação dos
conteúdos. Como consequência, maior domínio de conhecimentos para a prática
profissional.